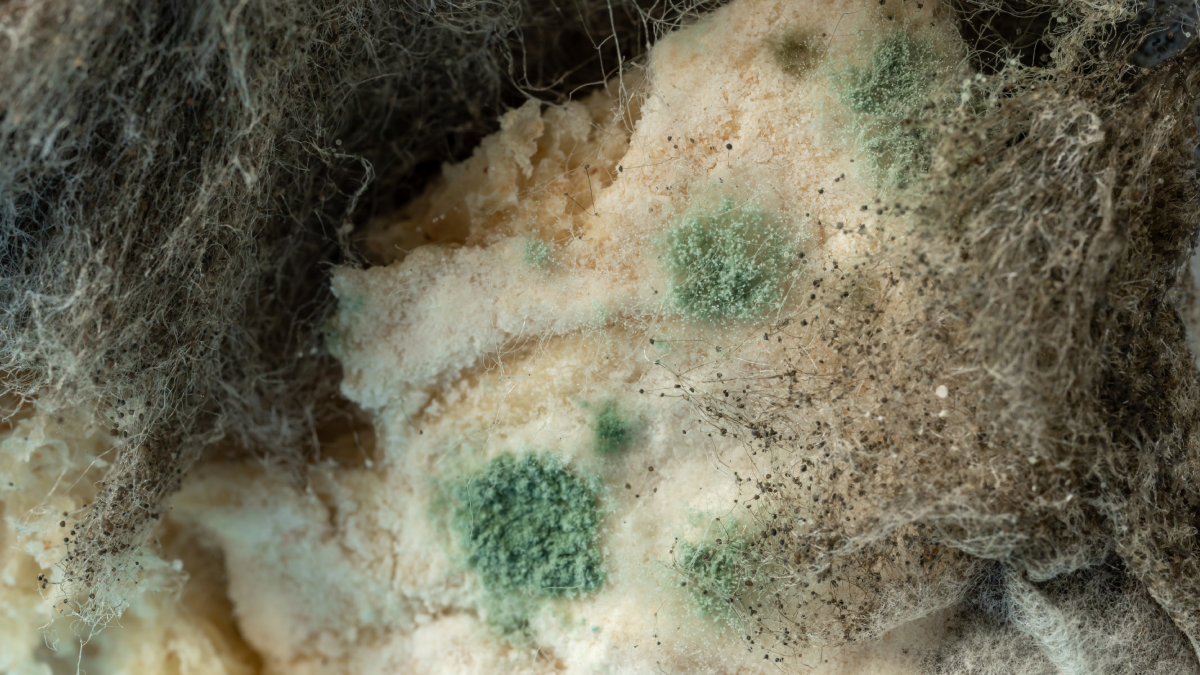

Manchester Üniversitesi'nden araştırmacılar, küresel ısınmadan dolayı ölümcül olarak adlandırılan Aspergillus fumigatus ve Aspergillus flavus gibi mantar türlerinin yayılımını artırabileceğini belirtti.

Bağışıklık sistemi zayıf bireylerde ölümcül akciğer hastalığına yol açan Aspergillus fumigatus, bu mantarın 2100 yılına kadar yaşam alanın yüzde 77 oranında genişleteceğini belirtti.
DİZİ ÜRÜNÜYDÜ GERÇEK OLABİLİR
"The Last of Us" dizisinde, Cordyceps mantarının insanları zombilere dönüştürdüğü bir senaryo işleniyor. Gerçekte, Cordyceps mantarı böcekleri enfekte ederek davranışlarını kontrol edebiliyor. Bilim insanları, mantarların insan vücudu sıcaklığına uyum sağlama yeteneklerinin artmasıyla, benzer tehditlerin ortaya çıkabileceğini belirtiyor.